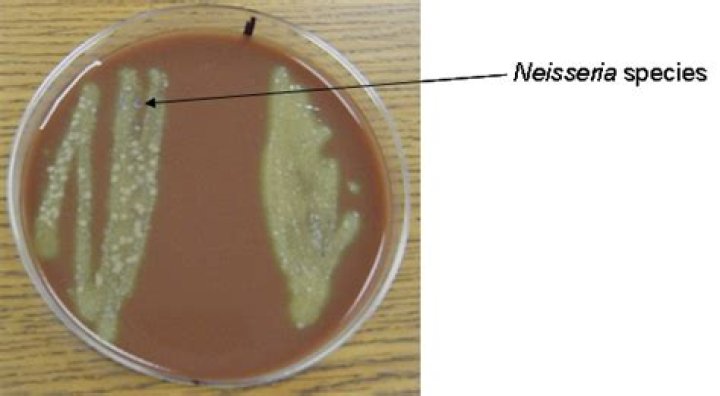

Is Neisseria normal flora
Most Neisseria and related species are normal flora in humans and animals (Table 2); their host range is shown in Table 2.
Where can Neisseria meningitidis be found?
N. meningitidis bacteria are found in the nose and throat without causing disease.
What type of organism is Neisseria meningitidis?
N. meningitidis is a gram-negative β proteobacterium and member of the bacterial family of Neisseriaceae. N. meningitidis is a fastidious bacterium, dying within hours on inanimate surfaces, and is either an encapsulated or unencapsulated, aerobic diplococcus with a “kidney” or “coffee-bean” shape (Fig.
Where is Neisseria found?
The Gram-negative bacteria genus Neisseria includes both pathogenic and commensal species that are found primarily in the upper respiratory tract of humans and animals.What are the normal flora of the gastrointestinal tract?
The digestive system contains normal microbiota, including archaea, bacteria, fungi, protists, and even viruses. Because this microbiota is important for normal functioning of the digestive system, alterations to the microbiota by antibiotics or diet can be harmful.
Is Neisseria meningitidis common?
Every year, about 2,500 to 3,500 people become infected with N. meningitidis in the US, with a frequency of about 1 in 100,000. Children younger than 5 years are at greatest risk, followed by teenagers of high school age.
Is Mycobacterium tuberculosis normal flora?
Mycobacterium tuberculosis is a fairly large nonmotile rod-shaped bacterium distantly related to the Actinomycetes. Many non pathogenic mycobacteria are components of the normal flora of humans, found most often in dry and oily locales. The rods are 2-4 micrometers in length and 0.2-0.5 um in width.
Is Neisseria meningitidis aerobic or anaerobic?
The human pathogen Neisseria meningitidis is the major causative agent of bacterial meningitis. The organism is usually treated as a strict aerobe and is cultured under fully aerobic conditions in the laboratory.Is Neisseria meningitidis viral or bacterial?
Bacteria called Neisseria meningitidis cause meningococcal disease. About 1 in 10 people have these bacteria in the back of their nose and throat without being ill. This is called being ‘a carrier’. Sometimes the bacteria invade the body and cause certain illnesses, which are known as meningococcal disease.
Is Neisseria a Coccu or bacilli?Neisseria meningitidis is a member of the family Neisseriaceae, which are gram-negative coccal, coccoid or rod shaped bacteria that lack flagella and usually possesses an outer capsule, and the genus Neisseria Dankert (1999). The genus Neisseria contains 3 species from animal sources and 11 from human sources. N.
Article first time published onIs Neisseria meningitidis Gram-negative?
N. meningitidis are gram-negative, coffee-bean shaped diplococci that may occur intracellularly or extracellularly in PMN leukocytes.
Is Neisseria meningitidis encapsulated?
Neisseria meningitidis meningitidis organisms are encapsulated, or surrounded by a polysaccharide capsule. This capsular polysaccharide is used to classify N. meningitidis into 12 serogroups. Six of these serogroups cause the great majority of infections in people: A, B, C, W135, X, and Y (12).
Is Neisseria meningitidis intracellular or extracellular?
To cause meningitis the extracellular pathogen Neisseria meningitidis has to traverse the blood-cerebrospinal fluid (B-CSF) barrier. Postulating a transcellular passage, meningococci (MC) have been shown to adhere to and enter B-CSF barrier forming human brain microvascular endothelial cells (HBMEC).
Is Neisseria meningitidis intracellular?
The Neisseria meningitidis Capsule Is Important for Intracellular Survival in Human Cells | Infection and Immunity.
What are the characteristics of Neisseria meningitidis?
CHARACTERISTICS: Neisseria meningitidis belongs to the family Neisseriaceae 2. It is a Gram-negative, non-spore forming, non-motile, encapsulated, and non acid-fast diplococci, which appears in kidney bean shape under the microscope 1 3.
What is the role of normal intestinal bacterial flora?
It is now recognized that the intestinal flora plays important roles in angiogenesis and maintenance of mucosal barrier integrity. Luminal bacteria interact with epithelial cells and other cells of the innate immune system and may alter immune responses to pathogenic bacteria, and regulate inflammation in the gut.
What microorganisms compose the normal microbiota of the stomach?
At the genera level, the healthy human stomach is dominated by Prevotella, Streptococcus, Veillonella, Rothia and Haemophilus; however, the composition of the gastric microbiota is dynamic and affected by such factors as diet, drugs and diseases.
What are normal flora How do normal flora affect human health?
The normal flora prevent colonization by pathogens by competing for attachment sites or for essential nutrients. This is thought to be their most important beneficial effect, which has been demonstrated in the oral cavity, the intestine, the skin, and the vaginal epithelium.
Which microbes are responsible for tuberculosis and measles?
Infectious diseaseMicrobe that causes the diseaseType of microbeGerman measlesRubellaVirusWhooping coughBordatella pertussisBacteriumBubonic plagueYersinia pestisBacteriumTB (Tuberculosis)Mycobacterium tuberculosisBacterium
Is mycobacteria Gram-positive or negative?
Mycobacteria are Gram-positive, catalase positive, non-motile, non-spore forming rod-shaped bacteria (0.2–0.6 μm wide and 1.0–10 μm long). The colony morphology of mycobacteria varies with some species growing as rough or smooth colonies.
How does Mycobacterium tuberculosis differ from other bacterial cells?
Tuberculosis is caused by Mycobacterium Tuberculosis H37Rv (MTB) which is a unique acid fast gram positive bacterium. It is unique because of its high lipid and mycolic acid content of its cell wall. It neither contains phospholipid outer membrane nor retains dye.
Is Neisseria meningitidis rare?
Meningococcal infections are usually uncommon, but potentially fatal. More specifically: The Centers for Disease Control and Prevention (CDC) estimates 2,600 cases of invasive meningococcal disease in the United States each year.
Is Neisseria meningitidis a commensal?
Neisseria meningitidis is a harmless commensal bacterium finely adapted to humans. Unfortunately, under “privileged” conditions, it adopts a “devious” lifestyle leading to uncontrolled behavior characterized by the unleashing of molecular weapons causing potentially lethal disease such as sepsis and acute meningitis.
Does Neisseria meningitidis flagella?
Neisseria meningitidis is a member of the family Neisseriaceae, which are gram-negative coccal, coccoid or rod shaped bacteria that lack flagella and usually possesses an outer capsule, and the genus Neisseria Dankert (1999). The genus Neisseria contains 3 species from animal sources and 11 from human sources.
Can you get meningitis from kissing?
Is meningitis contagious? Close contact – not casual contact at work or school – can spread the bacteria and viruses that cause meningitis. This includes kissing, coughing, or sneezing. Sharing eating utensils, glasses, food, or towels can also spread these bacteria and viruses.
How common is bacterial meningitis?
How common is bacterial meningitis? Approximately 3,000 people in the United States — or one in 100,000 — are diagnosed with bacterial meningitis each year, most of them infants, children, college students and the elderly. Incidences of bacterial meningitis usually peak in the winter or early spring.
How does Neisseria meningitidis cause meningitis?
Meningococcal meningitis evolves when the bacteria, Neisseria meningitidis (N. meningitidis) progresses from initial adherence to the nasopharyngeal (nose and throat) mucosa to invasion of the deeper mucosal layers (the submucosa). These bacteria rapidly multiply, and can lead to a mild (subclinical) infection.
Does Neisseria meningitidis form endospores?
Neisseria meningitidis is a parasitic, aerobic, Gram-negative, non endospore forming, nonmotile (although piliated) , coccal bacterium that is responsible for causing meningitis, inflammation of the meninges layer covering the brain.
Is Neisseria meningitidis an obligate parasite?
Biology and pathogenesis of the evolutionarily successful, obligate human bacterium Neisseria meningitidis.
Is Neisseria sicca aerobic?
Neisseria are typically considered as aerobic organisms but have since been shown in both N. meningitidis and N.
Is Neisseria oxidase positive or negative?
Neisseria species are gram-negative, oxidase-positive bacteria. All are catalase positive, except some strains of N.



